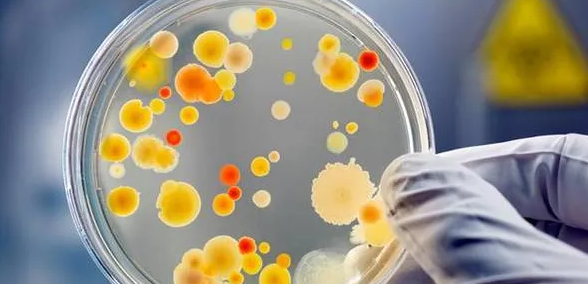
微生物領域的sci期刊盤點

微生物領域的sci期刊盤點
sci作為國際核心刊物,收錄的期刊領域涉及到方方面面,就算是簡單的說明微生物領域的刊物也是非常廣泛,這也是讓不少的作者感到很苦惱。所以這里也是給大家盤點了一些微生物領域的sci期刊,大家可以從中挑選合適自己的。
1. CELLULAR MICROBIOLOGY
Bimonthly
ISSN: 1462-5814
BLACKWELL PUBLISHING, 9600 GARSINGTON RD, OXFORD, ENGLAND, OXON, OX4 2DQ
2. CURRENT OPINION IN BIOTECHNOLOGY
Bimonthly
ISSN: 0958-1669
CURRENT BIOLOGY LTD, 84 THEOBALDS RD, LONDON, ENGLAND, WC1X 8RR
3. ANNUAL REVIEW OF MICROBIOLOGY
Annual
ISSN: 0066-4227
ANNUAL REVIEWS, 4139 EL CAMINO WAY, PO BOX 10139, PALO ALTO, USA, CA, 94303-0139
4. EUROPEAN JOURNAL OF CLINICAL MICROBIOLOGY & INFECTIOUS DISEASES
Monthly
ISSN: 0934-9723
SPRINGER, 233 SPRING STREET, NEW YORK, USA, NY, 10013
5. JOURNAL OF BIOTECHNOLOGY
Semimonthly
ISSN: 0168-1656
ELSEVIER SCIENCE BV, PO BOX 211, AMSTERDAM, NETHERLANDS, 1000 AE
6. ANTONIE VAN LEEUWENHOEK INTERNATIONAL JOURNAL OF GENERAL AND MOLECULAR MICROBIOLOGY
Bimonthly
ISSN: 0003-6072
SPRINGER, VAN GODEWIJCKSTRAAT 30, DORDRECHT, NETHERLANDS, 3311 GZ
7. APPLIED AND ENVIRONMENTAL MICROBIOLOGY
Monthly
ISSN: 0099-2240
AMER SOC MICROBIOLOGY, 1752 N ST NW, WASHINGTON, USA, DC, 20036-2904
8. MICROBIOLOGY AND IMMUNOLOGY
Monthly
ISSN: 0385-5600
CENTER ACADEMIC PUBL JAPAN, 2-4-16 YAYOI, BUNKYO-KU, TOKYO, JAPAN, 113-0032
9. EXTREMOPHILES
Bimonthly
ISSN: 1431-0651
SPRINGER TOKYO, 3-3-13, HONGO, BUNKYO-KU, TOKYO, JAPAN, 113-0033
10. ARCHIVES OF VIROLOGY
Monthly
ISSN: 0304-8608
SPRINGER WIEN, SACHSENPLATZ 4-6, PO BOX 89, WIEN, AUSTRIA, A-1201
11. BIOLOGICALS
Quarterly
ISSN: 1045-1056
ACADEMIC PRESS LTD ELSEVIER SCIENCE LTD, 24-28 OVAL RD, LONDON, ENGLAND, NW1 7DX
12. BIOTECHNOLOGY AND BIOENGINEERING
Semimonthly
ISSN: 0006-3592
JOHN WILEY & SONS INC, 111 RIVER ST, HOBOKEN, USA, NJ, 07030
13. BIOTECHNOLOGY LETTERS
Semimonthly
ISSN: 0141-5492
SPRINGER, VAN GODEWIJCKSTRAAT 30, DORDRECHT, NETHERLANDS, 3311 GZ
14. INTERNATIONAL JOURNAL OF ANTIMICROBIAL AGENTS
Monthly
ISSN: 0924-8579
ELSEVIER SCIENCE BV, PO BOX 211, AMSTERDAM, NETHERLANDS, 1000 AE
15. CANADIAN JOURNAL OF MICROBIOLOGY
Monthly
ISSN: 0008-4166
NATL RESEARCH COUNCIL CANADA-N R C RESEARCH PRESS, BUILDING M 55, OTTAWA, CANADA, ON, K1A 0R6
以上僅僅是對一小部分微生物領域的sci期刊的盤點,由于篇幅的原因這里就不一一為大家展現了,如果想要了解更多,或不確定具體選擇哪個,可以詢問一下本站在線編輯,會為您一一進行解答。






